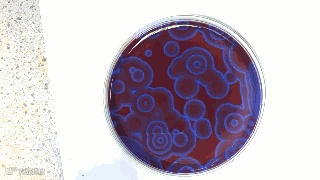

化学的神奇魅力可是不是随便说说的,神奇起来让人叹为观止。下面37张动图,在带领你领略化学之美的同时,也希望能帮助你理解这些化学现象。
1 . 硫氰酸汞分解(“法老之蛇”)
2Hg(SCN)2→ 2HgS + CS2 + C3N4
CS2 + 3O2 → CO2 + 2SO2
2C3N4 → 3(CN)2 + N2
花絮:硫氰酸汞于1821年由德国人合成,之后不久它燃烧的特殊现象就被发现。很长一段时间里作为一种焰火在德国出售,但是最终因为多例小孩误食而中毒的事故被禁止。
危险:高。汞化合物有毒,反应产生的硫化汞、二氧化硫和氰气也有毒。没有通风橱和专业人士指导,切勿自行尝试!
原理:火柴头包含红磷、硫和氯酸钾。擦火柴时产生的热量使红磷和硫燃烧、氯酸钾分解出氧气辅助燃烧。
花絮:最早的摩擦式火柴头上只有硫,1826年英国化学家约翰·沃克首先使用了氯酸钾,但他的火柴非常危险,经常有火球掉下去把衣服和地毯点着。
危险:中。由于爆炸可能伤人,请像图中那样遥控点燃。
原理:铝是高度活泼的金属,但是表面的氧化铝层阻止了它和空气中氧气完全反应。而汞会破坏这一保护层,使得铝迅速“生锈”。
这是一段延时摄影。该过程真实长度约半小时。如果画面下移,你会看到底下有一大堆铝锈粉末。
花絮:这是飞机上严禁携带水银的原因之一。有传说称二战时一些美军突击队员会携带汞用来破坏德国飞机。
危险:中低。汞单质有毒,不可食用,请在空气流动通畅的地方实验以免汞蒸汽中毒。
原理:将除锈处理后的铁棒放入硫酸铜溶液中,铁单质比铜更加活泼,置换出来的铜形成漂亮的松散沉淀。
溶液原本是蓝色的(水合铜离子颜色),随着反应进行,蓝色逐渐变淡。
花絮:铜离子本身并没有蓝色,无水硫酸铜是白色粉末。水溶液中蓝色的是六水合铜离子。
原理:燃烧需要可燃物和氧气接触,狭窄的瓶口使得氧气只能逐渐进入,燃烧面逐渐下移。
原理:常温下镁与水其实就可以反应,但除非是镁粉,否则速度很慢。高温时二者会剧烈反应生成氧化镁和氢气。氢气继续燃烧,和燃烧的镁一起产生炫目的光影效果。
花絮:这个反应是日本设计的一种试验性发动机的基本原理。镁和水反应生成的氧化镁在激光的作用下重新分解成镁单质和氧气,整个反应只消耗水,而激光则由太阳光提供动力。不过这一发动机投入使用似乎还很遥远。
危险:中。镁燃烧时高温,遇水剧烈反应可能溅出红热液态镁导致烫伤。
原理:浅浅一层丙酮并不能真的把整块泡沫塑料“溶解”,实际上它只是溶解了聚苯乙烯的长链,让泡沫塑料里的大量空气逃逸出去。但是,长链交联的地方丙酮无能为力,所以碗底部还会剩下残存的聚苯乙烯。
危险:低。丙酮有一定毒性和挥发性,应在通风处实验,勿饮用。
原理:血液中有高效的过氧化氢酶,能够催化过氧化氢分解为水和氧气,大量氧气形成泡沫效果。
花絮:过氧化氢酶是一种非常常见的酶,几乎所有好氧生物体内都有发现。在细胞内它的主要作用是催化活性氧成为氧气,阻止它破坏细胞。过氧化氢酶也是所有酶中效率最高的酶之一,每个酶分子每秒钟可以催化数百万个过氧化氢分子。
危险:低至中。高浓度过氧化氢腐蚀性很强,但低浓度比较安全。没有其他威胁,除非你的血液来源有问题……
原理:这个反应的核心和上期里的血液反应一样,是过氧化氢分解。30%过氧化氢和液体肥皂混合,加入一些食用色素,再加入碘化钾作为催化剂。少量的过氧化氢就可产生大量氧气,在肥皂作用下形成泡沫涌出。
一种更加安全的版本是用低浓度(3%-6%)过氧化氢,用干酵母作为催化剂,原料更易得,但反应也没有那么剧烈。
花絮:反应后会有大量氧气聚集在瓶内,可以试着关灯然后往里丢一根火柴观察燃烧。小心火灾。
危险:低至中。浓过氧化氢腐蚀性强,处理时请戴手套。
原理:这是一个闪光灯泡,内装锌丝和氧气,通电即点燃,只能使用一次。外面包有一层塑料膜以防万一灯泡破碎。在现代电子闪光灯出现之前它是主要的闪光道具,抵达满亮度所花时间更长,但燃烧时间也更长。
此图在网上传播时很多人说它是灯泡烧断的瞬间,可惜普通钨丝灯泡到寿命时只会慢慢黯淡下去。
花絮:早期的闪光灯泡使用镁丝,亮度不如锌。更早的则是敞开环境下镁粉和氯酸钾混合点燃。这就是“镁光灯”一词的来历。
原理:铯是活泼的碱金属,和水爆炸式反应生成氢气。高速摄影需要极强的光,光照产生的高温使得铯无法保持固态,因此实验采用安瓿来装液态铯。小锤击碎安瓿瞬间,铯液滴倾泻而出,在空中就和水蒸气、氧气反应留下尾迹,大块入水后产生爆炸式反应。
花絮:在互联网上有这样一个钓鱼贴,“……爱迪生等得不耐烦了,拿过铯块,浸在水中,将溢出的水倒在了量杯里量出体积,就知道了铯块的体积。”也许这才是爱迪生耳聋的真正原因?
原理:这种液体是二乙基锌。它是一种极易燃烧的有机锌化合物,接触氧气便自燃。真正的二乙基锌如此图所示是蓝色火焰,但是网上流传最广的视频/动图来自2008年诺丁汉大学,他们拍到了黄色的火焰——照他们自己的说法,这是钠污染所致。
花絮:二乙基锌于1848年发现,是第一个有机锌化合物。它在有机合成中的应用极其广泛,也曾被早期火箭研究者用作液体燃料。
原理:外层红色粉末是重铬酸铵,它不稳定,受热分解可以产生大量暗绿色灰烬(三氧化二铬)和明亮的红色火焰。
(NH4)2Cr2O7 (s) → Cr2O3 (s)+ N2 (g)+ 4 H2O (g)
而藏在里面的就是上期介绍过的硫氰酸汞“法老之蛇”了。
花絮:重铬酸铵有个外号叫“维苏威之火”,就是因为它的这个效果。它在焰火和早期摄影术里都有应用。搭配硫氰酸汞感觉像是召唤了克苏鲁……
危险:高。重铬酸铵和所有六价铬一样有毒、有刺激性。密闭容器中受热可能导致爆炸。至于硫氰酸汞请参见上期。
原理:铝是极活泼的金属,因为表面致密氧化层而在空气中稳定,但会和很多其它氧化剂剧烈反应。溴就是其中之一。生成的三溴化铝溶于水的反应也会放热,可能导致爆炸。实验完的试管必须先冷却然后用轻柔的水流慢慢溶解,清洗后还要加入硫代硫酸钠溶液以还原任何残留的溴。
花絮:“三溴化铝”真正的存在形态其实是Al2Br6,它十分稳定,哪怕气化之后也只有一部分会分解成AlBr3。
危险:高。溴有挥发性和腐蚀性,吸入有毒,需防护措施。反应剧烈且有喷溅,请务必从少量开始!
原理:黑咖啡可不会变成这东西。杯中是对硝基苯胺和浓硫酸的混合物,加热后发生非常复杂的反应——事实上,我们还不完全清楚反应的详细过程。最后得到的黑色泡沫物原子比例为C6H3N1.5S0.15O1.3,几乎肯定是对硝基苯胺交联后的多聚物,整个反应有时被称为“爆炸式聚合”。膨胀成这么大这么长是反应生成二氧化碳等气体的功劳。
花絮:这个反应是70年代NASA研究者发现的,他们当时考虑过把它用作灭火剂——因为生成的黑色泡沫状物非常稳定,隔热性能也极好。
危险:中高。对硝基苯胺有毒,浓硫酸也有危险,反应还生成氮氧化物和硫氧化物气体。
原理:这是“碘钟反应”的一个变种。实验中所用到的三种无色透明溶液(从前到后)分别加入了:
1、焦亚硫酸钠与水反应生成亚硫酸氢钠 Na2S2O5+ H2O → 2 NaHSO3
2、亚硫酸氢钠将碘酸根还原为碘离子 IO3- + 3HSO3-→ I- + 3SO42- + 3H+
3、随着碘离子浓度的升高,可溶性的汞盐开始与碘离子形成碘化汞沉淀(橙红色)Hg2++ 2 I-→ HgI2
4、剩余的碘离子与碘酸根离子生成碘单质 IO3- + 5I- + 6H+→ 3I2 + 3H2O
花絮:这个改良版的反应由两名普林斯顿大学的学生发明,他们在其中加入了汞盐,使这个反应可以先后形成橙红色和黑色,而橙黑配正是普林斯顿大学的代表色。这个反应通常被称为“Old Nassau Reaction”,其中“Old Nassau”指的就是普林斯顿大学[1]。因为颜色的缘故,它也被叫做“万圣节反应”。
危险:高。氯化汞毒性很强,吸入、皮肤接触或误食时均有较高风险,请勿在家尝试。
原理:铜与浓硝酸反应,生成硝酸铜、二氧化氮和水,生成的气体通入水中,随着气体生成停止并逐渐溶解,水倒吸进入反应瓶,最终形成淡蓝色的硝酸铜溶液。
Cu(s) + 4HNO3(aq)→ Cu(NO3)2(aq)+2NO2(g) + 2H2O(l)
一开始出现的绿色与浓酸条件下铜离子与硝酸根的结合有关[2],而在引入更多水之后,溶液就显示为水合铜离子的蓝色了。
花絮:铜和浓硝酸大概是最难背的高中化学反反应了……等等,还有稀硝酸。你还记得怎么配平吗?
录制者:Royal Societyof Chemistry
危险:中,浓硝酸具有较强腐蚀性,推荐使用手套和护目镜。二氧化氮气体有毒,不过在该实验中大部分生成气体都会被水吸收。后半部分倒吸造成的“喷泉”现象有较小的造成烧瓶损坏的风险,如果在开放实验室中进行,应使用安全屏保护观众。
原理:这是金属锂燃烧的景象,燃烧过程中固态的金属锂不断熔化,并生成氧化锂。锂的焰色反应为红色,但当剧烈燃烧时火焰呈现一种“亮银色”的状态。
花絮:和其他碱金属一样,锂火不能用水来扑灭,需要专门的干粉灭火剂。
原理:试管中是加热到熔融状态的氯酸钾,氯酸钾发生热分解产生氧气,试管中的氧气和热足以点燃小熊软糖中的糖类等有机物。氧气促进燃烧,而燃烧产生的热量又进一步促进氯酸钾分解产生更多氧气,因此就产生了剧烈的燃烧反应。
花絮:这个实验还有一个更加丧心病狂的超大号版本(原视频录制者:Vat19):
危险:高。反应非常剧烈,尤其是超大号版本绝对不建议在家尝试(浪费食物不是好孩子!)。
原理:这是硝酸铅与碘化钾发生的复分解反应,其中析出的金黄色结晶为碘化铅。反应式:Pb(NO3)2+ 2KI → 2KNO3 + PbI2↓
花絮:碘化铅晶体是一种可以用于X射线和γ射线探测的材料。
录制者:Thoisoi2 -Chemical Experiments!
原理:这是一个发生在平皿薄层上的B-Z反应(Belousov-Zhabotinsky反应)的例子。B-Z 反应是一种化学震荡反应,它最早在20世纪50年代被发现。反应体系会在两种状态之间不断进行周期性变化,平皿上的“波纹”也会不断变换。B-Z反应有多 种版本,上图中是它的一个常见版本,溴酸盐与丙二酸发生氧化还原反应,以铈盐及邻二氮菲亚铁离子(ferroin,在还原态为红色,氧化态为蓝色)作为催 化剂和反应指示剂。
花絮:目前,对B-Z反应的动力学研究依然在进行中,研究者们也对反应过程进行了很多数学计算。下面就是一个计算机模拟出的平皿B-Z反应的图像,是不是感觉更加魔性了呢……
危险:中低。反应本身并不剧烈,不过溴酸盐对人具有刺激性,配制反应溶液时依然要注意防护。
原理:在硅酸钠的水溶液中加入一些金属盐类的结晶颗粒(例如铜盐、钴盐等),就可以观察到溶液中树枝状的结构逐渐“生长”的过程。投入的结晶颗粒逐渐溶解,释放出金属离子,而这些金属离子又会与硅酸钠形成难以溶解的硅酸盐结晶,沉积在最初的结晶颗粒之上。而且,各种过渡金属离子的硅酸盐还可以呈现不同的颜色,使花园更加美丽。以下是“花园”中常用的一些反应物和对应的硅酸盐颜色:
花絮:如果把化学花园搬到太空中会是什么样?NASA曾在国际空间站上进行过实验[1,2]:
原理:这是氢化钠与水发生的反应,生成氢氧化钠和氢气,溶液中加入了酚酞作为指示剂,因此呈现紫红色。
花絮:氢化钠是一种碱性非常强的物质,它可以夺取很多化合物中的质子形成相应的钠化合物,这在有机合成中非常实用。
原理:碘单质与金属铝的粉末混合,并加入少量水即可引发剧烈反应。主要反应式:2Al(s) + 3I2(s) → Al2I6(s),水在其中起到催化剂的作用。随着反应进行,碘单质也会升华形成紫色的碘蒸气。
花絮:说到铝粉,最让人印象深刻的大概就是铝热反应了,下面就让我们来重温一下:
危险:中高。反应剧烈,碘蒸气具有刺激性,应注意保护眼部,并在通风橱中进行。加水后反应可能需要稍等片刻才会开始,此时不要着急凑近查看。
原理:在加热至高温时,白色的氧化锌粉末会逐渐变成金黄色,在空气中冷却时颜色又会褪去。产生颜色的原因是高温下氧化锌晶体失去部分氧原子,从而形成晶格缺陷。
花絮:很多宝石的色彩也与晶格缺陷有关,例如彩色的钻石。
危险:中高。观察氧化锌变色需要将其加热到800℃左右[3],使用高温火焰需要格外当心。
原理:鲁米诺(3-氨基邻苯二甲酰肼)是一种常用的发光化学试剂。在演示实验中,一般用双氧水和一种氢氧化物碱 (例如氢氧化钠)的溶液作为激发剂,并用含铁化合物催化过氧化氢分解。鲁米诺与氢氧化物反应生成了一个双负离子,这个离子又可以与过氧化氢分解产生的氧气反应,生成激发态的3-氨基邻苯二甲酸,当它回到基态时,就会发出蓝色的光。
花絮:估计不少人都是从刑侦剧或者推理小说中听说鲁米诺试剂的,如果将上述反应中的催化剂换成血液中的铁,这也就成了一个检测痕量血迹的反应。
原理:在纸片的不同位置上事先分别滴上了浓盐酸和浓氨水,这两种东西都有极强的挥发性,而它们在空气中相遇也会形成氯化铵,营造出烟雾效果。
花絮:另外一个常见的演示实验“氨气喷泉”展示了这种气体在水中极强的溶解性。当瓶中的氨气接触含有酚酞的水时,它们迅速溶解造成瓶内压强减小,形成粉色的倒吸喷泉:
危险:较低,不过浓盐酸和浓氨水具有刺激性,需要注意通风,避免吸入。
原理:右边两个表面皿中的固体和液体分别是高锰酸钾与浓硫酸。在这里,浓硫酸表现出了它的“脱水性”,它与高锰酸钾固体反应,生成了七氧化二锰(高锰酐)。七氧化二锰是一种不稳定的强氧化物,当它接触到棉花时,可以与之反应并造成燃烧。
花絮:在历史上,硫酸也曾经被用于引燃火柴。第一个现代意义上的火柴是1805年时让·斯尔(JeanChancel)发明的,火柴头上加入了氯酸钾、硫磺、糖等物质,使用时需要在装硫酸的小瓶中浸一下引发反应。
危险:中高,浓硫酸需要格外小心操作,注意防护并远离易燃物,需要在通风良好处进行。高锰酐具有腐蚀性、强氧化性和爆炸性,实验时应佩戴护目镜或面罩,并保证只进行少量混合。不要擅自增加反应物量或用其他有机物反应,因为反应可能会过于剧烈。
录制者:royalchemistry society
原理:这是生成聚氨酯泡沫材料的反应,原料包括异氰酸酯、多元醇以及发泡剂等助剂。聚氨酯(PU)是指主链中含有氨基甲酸酯特征单元的一类高分子,它们化学性质稳定,而且力学性能也有很大的可调性,因此在工业和生活中都有广泛的应用。聚氨酯泡沫可以作为保温材料使用。
花絮:举个例子,就能让你体会到聚氨酯的“戏路”有多广:市面上的人造皮革制品大多是聚氨酯材质的,而最常见的非乳胶型避孕套所用的也是聚氨酯,它还可以做成沙发软垫和鞋底。
危险:较低,应注意避免吸入,避免接触皮肤和眼睛。聚氨酯泡沫本身是相当易燃的,因此很多商业产品都会预先加入阻燃剂。
原理:镁条点燃后放在干冰当中,反应式:2Mg +CO2→ 2MgO + C
花絮:最早的闪光灯就利用了镁发出的强光,因此它也被称为“镁光灯”。
危险:高。反应过程中,有火花溅出的可能,需要移除附近所有的可燃物,并使用防护隔板。
录制者:Grant Thompson- "The King of Random"
原理:瓶中的溶液加入了3种成分:氢氧化钠、D-葡萄糖和靛蓝胭脂红(indigo carmine,或称酸性靛蓝)。靛蓝胭脂红是一种氧化还原指示剂,而同时它又有酸碱指示剂的作用,也就是说,在氧化还原反应和pH值的作用下,它可以变 幻出多种颜色。靛蓝胭脂红有三种颜色不同的氧化还原状态,在这个反应体系中,当振摇瓶子时,它会被空气中的氧气氧化,而在静置时又被葡萄糖还原,由此就造成了变色。如果在不同的pH环境中进行反应,颜色也会随之改变。下图中总结了具体的变色状态:
花絮:除了指示剂,靛蓝胭脂红还有别的用途。它是一种食品色素(E132),在一些泌尿系统手术中也会用到它。
危险:低。在这里氢氧化钠起到调节pH的作用,不会用到很浓的溶液,葡萄糖和靛蓝胭脂红也比较安全。
录制者:royalchemistry society
原理:试管下面橙色的部分是加入了一些硫酸的重铬酸钾溶液,上面透明的部分是乙醚,引发反应时在其中加入了一些双氧水。接下来,体系内会发生剧烈的反应,上面的有机层变成蓝色,并产生气体。
当加入过氧化氢时,水相中会发生如下反应:K2Cr2O7+ H2SO4 + H2O2 → 2CrO5 + K2SO4 + 5H2O。这里生成的过氧化铬(CrO5,又叫五氧化铬)是一种不稳定的过氧化物,它可以溶于乙醚,并带来深蓝色。而不稳定的过氧化铬还会继续发生反应,生成三价铬盐:2CrO5 + 7H2O2 + 3H2SO4 → Cr2(SO4)3+ 10H2O + 7O2,试管中冒出的气泡就是这步反应中产生的氧气[1]。
花絮:过氧化铬在水溶液中也是蓝色的,只不过通过乙醚萃取,可以让蓝色保持较长的时间,以方便观察。
危险:中高,反应剧烈,需要戴好手套和护目镜,不要把试管装得太满。
录制者:Thoisoi2 - Chemical Experiments!
来源:化学之家
声明:本文所用视频、图片、文字如涉及作品版权问题,请第一时间告知,我们将根据您提供的证明材料确认版权并按国家标准支付稿酬或立即删除内容!010-88379790转811

来源:“通用机械”公众号,欢迎阅读原文。